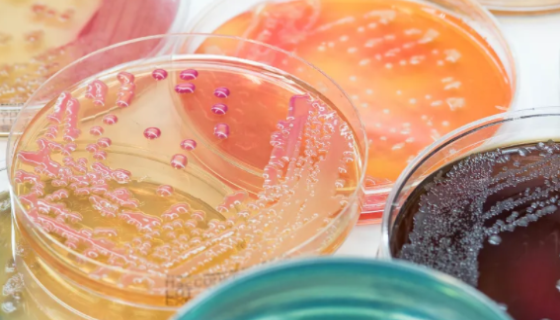
胰化蛋白胨葡萄糖培养基（TGEA）的配制与使用方法！

人骨骼肌细胞永生化的运输和保存及使用方法!
人骨骼肌细胞分离自四肢肌肉组织;骨骼肌又称横纹肌,肌肉中的一...

鲍曼不动杆菌的培养特性与生化反应及鉴定方法!
鲍曼不动杆菌为不动杆菌属中最常见的一种革兰阴性杆菌,广泛存在...

鼠李糖乳杆菌的培养条件与注意事项及打管说明!
鼠李糖乳杆菌( Lactobacillus rhamnosu...

RM-1+LUC 小鼠前列腺癌细胞的处理方法与培养步骤!
小鼠前列腺癌细胞为稳定转染Luc的细胞,随细胞传代次数的增加...

脓肿分枝杆菌的培养条件与注意事项及保藏方法!
脓肿分枝杆菌(M.abscessus)是一种快速生长的非典型...

绿色魏斯氏菌的培养方法与使用范围及主要价值!
绿色魏斯氏菌是Weissella属的微生物,原产地为中国。是...

人胰岛β细胞的培养与分离方法及质量检测!
人胰岛β细胞分离自胰腺组织;胰腺分为外分泌腺和内分泌腺两部分...

产朊假丝酵母的性质、用途与生产工艺!
产朊假丝酵母(Candida utilis)又叫产朊圆酵母或...
胰化蛋白胨葡萄糖培养基(TGEA)的配制与使用方法!
胰化蛋白胨葡萄糖培养基(TGEA)适用于一般性细菌培养。用于...